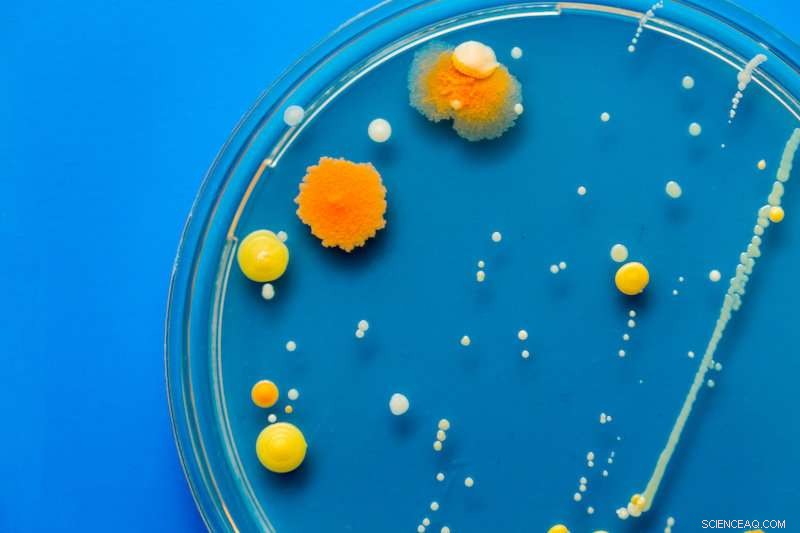
Unveiling How Killer Immune Cells Outsmart Bacteria

Credit: Children's Hospital Boston
Immune cells called "killer cells" target bacteria invading the body's cells, but how do they do this so effectively? Bacteria can quickly evolve resistance against antibiotics, yet it seems they have not so readily been able to evade killer cells. This has caused researchers to become interested in finding out the exact mechanism that killer cells use to destroy bacterial invaders.
Although one way that killer cells can trigger bacterial death is by inflicting oxidative damage, it has not yet been at all understood how killer cells destroy bacteria in environments without oxygen.
Now, for the first time, researchers have caught killer cells red-handed in the act of microbial murder, observing them as they systematically killed three strains of microbes: E. coli and the bacteria responsible for causing Listeria infection and tuberculosis. The process inflicts bacterial cell death regardless of whether the environment contains oxygen or not.
Their findings, published in Cell, reveal that killer cells act methodically, shooting deadly enzymes into bacteria to "program" a complete internal breakdown and cell death.
The researchers, from Boston Children's Hospital, the Wistar Institute and the University of Michigan (U-M), used an equally systematic approach to make the discovery.
"We took three bacteria that are very different—and to see which proteins were destroyed by killer cells—we measured their protein levels before, during and after they were attacked," says Judy Lieberman, MD, PhD, of Boston Children's Program in Cellular and Molecular Medicine (PCMM), who is co-senior author on the study.
Proteins are critical to life because they direct the use of nutrients and production of cellular machinery that bacteria need to survive.

This cartoon, entitled "Monkey Wrench", portrays how granzyme B targets and disrupts protein synthesis in bacteria. Here, bacterial protein synthesis is depicted as a processing line where granzyme B -- the group of disruptive monkeys -- shuts down essential systems in bacteria, causing catastrophe. Credit: Artwork by Sylvie Shaffer of the Wistar Institute.
"Each strain of bacteria has about 3,000 proteins and we saw that—in all three bacterial species—about five to 10 percent of those proteins were slashed by the killer cells' death-inducing enzyme, called granzyme B," Lieberman says. "If you made a list of the proteins that bacteria absolutely needed to survive, it would be a small list—interestingly, this seems to be identical to granzyme B's hit list."
Deadlier than antibiotics
To deliver the fatal blow of granzyme B, killer cells seek out surface markers on the body's cell surfaces that might indicate a bacterial invader has taken up residence inside the cell. Killer cells then latch onto the infected cell and use an enzyme to create a small pore in the cell's surface, through which they inject granzyme B. Once granzyme B gets into the cell, it passes into the invading bacterium and essentially destroys critical proteins for cell survival as well as its ribosomes, the pieces of bacteria's cellular machinery that actually make proteins.
"The bacteria's ribosomes fall apart and stop functioning," says Lieberman, also a professor of pediatrics at Harvard Medical School.
It's as if the bacteria's internal factory of life not only loses the blueprints for the parts it needs to make, but also suffers a catastrophic mechanical failure of its assembly line.
"By discovering the bacterial proteins that killer cells 'take out,' we have identified potential therapeutic targets that could pave the way for a new class of antimicrobial drugs," Lieberman suggests.
"We have a huge crisis of antibiotic resistance right now in that most drugs that treat diseases like tuberculosis or listeria, or pathogens like E.coli, are not effective," said Sriram Chandrasekaran, PhD, co-senior author of the study from U-M, in a press release. "So, there is a huge need for figuring out how the immune system does its work. We hope to design a drug that goes after bacteria in a similar way."
Importantly, no matter how many times the researchers exposed the bacteria to granzyme B, the bacteria did not develop resistance to its fatal attack. It's possible that the only way bacteria can survive is to camouflage themselves so that killer cells cannot "see" them and shoot granzyme B into them.
Lieberman is now searching for the specific mechanisms by which bacteria might evade killer cells. She's also investigating how similar "death pathways" take effect in fungi and parasites, such as those that cause malaria.